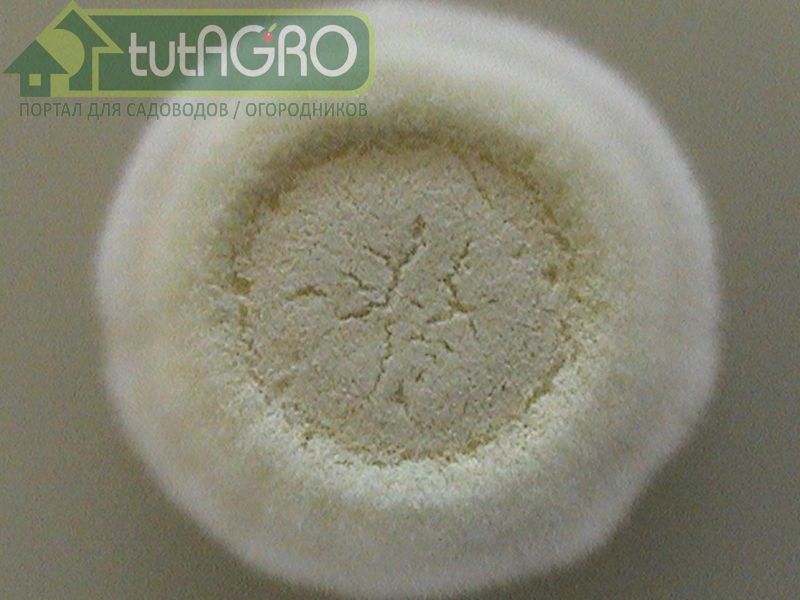
Знакомьтесь - Боверия. Обзор субстратов для защиты растений - AGROzen

Во всем мире биологическая защита растений от болезней и вредителей становится все более и более популярной. И это не удивительно, ведь применение препаратов на биологической основе не только эффективно и ничуть не уступает защите с помощью токсических синтетических препаратов, но еще и является безопасным для окружающей среды и здоровья человека.
Многочисленные вредители садов и огородов с каждым годом все лучше адаптируются к средствам химзащиты и наносят порой непоправимый ущерб урожаю. А дачникам вместо отдыха на природе приходится беспрерывно бороться с такими вредителями как паутинный клещ, белокрылка, колорадский жук, плодожорка, личинки хрущей и сциарид (комариков), гусеницы, в том числе листовертки и совки, клопы, листоеды, стеклянницы, разнообразные мухи: луковая, порейная, морковная, кукурузный и рапсовый мотылек, капустная моль, цикадки, которые переносят столбур томата, и многие другие.

Особенно страдают от вредителей однолетние овощные растения (огурец, томат, баклажан, капуста, морковь, лук и чеснок), молодые посадки плодовых деревьев, земляника, смородина.

Для защиты всех растений от большого комплекса вредителей используется такой активный агент как гриб Боверия Басси. Этот гриб способен вызывать эпизоотию, то есть эпидемию, у широкого круга насекомых-вредителей и клещей, являясь в то же самое время безопасным для пчел и дождевых червей.
Два очень активных изолята Боверии, заражающих множество вредителей, входят в состав субстрата «Защитник сада и огорода Форте». Через несколько дней после попадания гриба на вредителя он заражает и губит его. Тело вредителя под действием гриба разлагается, возвращая питательные вещества растениям и тем самым повышая плодородие почвы. Образовавшиеся споры разлетаются по окрестностям и заражают новых вредителей, благодаря чему достигается длительный защитный эффект.

Изоляты грибов рода Боверия в составе субстрата «Защитник сада и огорода Форте»:
- могут заражать некоторые виды вредных нематод, что способствует их уничтожению и оздоровлению почвы, а также паразитировать на кровососущих комарах,
- способствуют борьбе с болезнями растений, особенно с опасным возбудителем гнилей и увяданий Фузариумом.

Боверия субстрата «Защитник сада и огорода Форте», как и триходерма субстрата «Друг садовода и огородника», способна сохраняться на растительных остатках, способствуя их компостированию и увеличению плодородия почвы.
Значительным усилением боверии является метаризиум, также входящий в состав препарата «Защитник сада и огорода Форте».
Автор: Иван Русских
Иван Русских рекомендует подписаться на журнал "Урожайные сотки"!
Только в журнале "Урожайные сотки" Вы можете получать дельные рекомендации, уникальные советы, рецепты от специалиста-биолога, известного блогера Ивана Русских.
Оформите подписку прямо сейчас! Жители Беларуси могут оформить подписку тут. Жители России сюда!